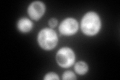
YDR353W
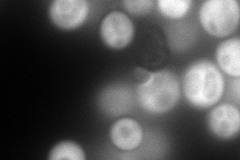
YDR353W
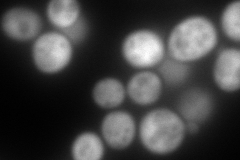
YDR353W
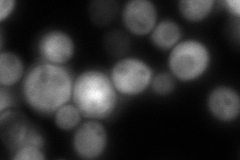
YDR353W
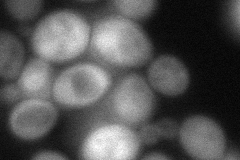
YDR353W
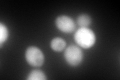
YDR353W
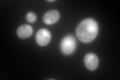
YDR353W

View description
Cytoplasmic thioredoxin reductase, key regulatory enzyme that determines the redox state of the thioredoxin system, which acts as a disulfide reductase system and protects cells against both oxidative and reductive stress
Localization:
Intensity:
Fold change:
Significance:
-
C’ GFP library in SD
cytosol312.58 -
N' NOP1pr-GFP in SD
cytosol285.571 -
N' TEF2pr-mCherry in SD
cytosol349.685 -
N' NATIVEpr-GFP in SD
cytosol289.285 -
N' TEF2pr-VC and Cyto-VN in SD
cytosol80.1817 -
C’ GFP library in SD+DTT
cytosol307.910.98No -
C’ GFP library in SD+H2O2

cytosol762.942.44Yes -
C’ GFP library in Starvation Media
nucleusN/AN/AYes -
C’ GFP library on the background of Pup2-DaMP

cytosol -
C’ GFP library on the background of CCT mutant

cytosol338.6611.08341No
